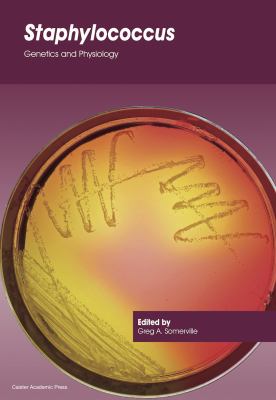
Staphylococcus : Genetics and Physiology

Shop By Department
- Business & Economics
- Accounting
- Banks & Banking
- Business Ethics
- Commerce
- Economic History
- Economics
- Finance
- Organizational Development
- Personal Finance
- Strategic Planning
- Taxation
- Auditing
- Business Communication
- Business Law
- Business Mathematics
- Business Writing
- Careers
- Commercial Policy
- Commodities
- Corporate & Business History
- Corporate Finance
- Customer Relations
- Decision-Making & Problem Solving
- Development
- E-Commerce
- Econometrics
- Economic Conditions
- Education
- Entrepreneurship
- Environmental Economics
- Exports & Imports
- Human Resources & Personnel Management
- Industrial Management
- Industries
- Insurance
- International
- Investments & Securities
- Knowledge Capital
- Labor
- Leadership
- Management
- Marketing
- Money & Monetary Policy
- Negotiating
- New Business Enterprises
- Nonprofit Organizations & Charities
- Office Automation
- Organizational Behavior
- Project Management
- Public Finance
- Public Relations
- Real Estate
- Sales & Selling
- Secretarial Aids & Training
- Statistics
- Training
- Workplace Culture
- Advertising & Promotion
- Business Etiquette
- Consulting
- Distribution
- Forecasting
- Foreign Exchange
- Free Enterprise
- Government & Business
- Inflation
- Management Science
- Mergers & Acquisitions
- Motivational
- Operations Research
- Purchasing & Buying
- Quality Control
- Reference
- Small Business
- Total Quality Management
- Budgeting
- Consumer Behavior
- Facility Management
- Green Business
- Home-Based Businesses
- Information Management
- Interest
- Museum Administration & Museology
- Office Equipment & Supplies
- Production & Operations Management
- Structural Adjustment
- Urban & Regional
- Office Management
- Skills
- Bookkeeping
- Infrastructure
- Mail Order
- Outsourcing
- Study Aids
- Armed Forces
- CLEP (College-Level Examination Program)
- CPA (Certified Public Accountant)
- Civil Service
- College Entrance
- GED (General Educational Development Tests)
- GMAT (Graduate Management Admission Test)
- GRE (Graduate Record Examination)
- LSAT (Law School Admission Test)
- NTE (National Teacher Examinations)
- SAT
- Tests
- Vocational
- College Guides
- Financial Aid
- ACT
- Advanced Placement
- Citizenship
- Graduate School Guides
- High School Entrance
- MCAT (Medical College Admission Test)
- PSAT & NMSQT (National Merit Scholarship Qualifying Test)
- TOEFL (Test of English as a Foreign Language)
- Biographies & Memoirs
- Children's Books
- Computers
- Digital Media
- Hardware
- General
- Internet
- Bioinformatics
- Computer Engineering
- Computer Graphics
- Computer Science
- Data Modeling & Design
- Data Processing
- Data Transmission Systems
- Database Management
- Desktop Applications
- Enterprise Applications
- Information Technology
- Information Theory
- Intelligence (AI) & Semantics
- Interactive & Multimedia
- Machine Theory
- Management Information Systems
- Mathematical & Statistical Software
- Natural Language Processing
- Networking
- Neural Networks
- Operating Systems
- Programming
- Programming Languages
- Security
- Social Aspects
- Software Development & Engineering
- Systems Architecture
- User Interfaces
- Virtual Worlds
- Web
- CAD-CAM
- Computer Simulation
- Computer Vision & Pattern Recognition
- Cybernetics
- Expert Systems
- History
- Image Processing
- Microprocessors
- Online Services
- Reference
- System Administration
- Compilers
- Document Management
- Electronic Publishing
- Speech & Audio Processing
- Buyer's Guides
- Calculators
- Certification Guides
- Client-Server Computing
- Computer Literacy
- Computerized Home & Entertainment
- Documentation & Technical Writing
- Electronic Commerce (see also headings under Business & Economics
- Keyboarding
- Logic Design
- Optical Data Processing
- Utilities
- Cooking
- Education & Teaching
- Literature & Fiction
- Medical
- Genetics
- Endocrinology & Metabolism
- Cardiology
- Dentistry
- Forensic Medicine
- General
- Gynecology & Obstetrics
- Hospital Administration & Care
- Immunology
- Internal Medicine
- Long-Term Care
- Nursing
- Nutrition
- Ophthalmology
- Pathology
- Pharmacy
- Physiology
- Public Health
- Reproductive Medicine & Technology
- Surgery
- Veterinary Medicine
- AIDS & HIV
- Allied Health Services
- Alternative Medicine
- Anatomy
- Anesthesiology
- Audiology & Speech Pathology
- Biostatistics
- Biotechnology
- Chemotherapy
- Clinical Medicine
- Critical Care
- Dermatology
- Diagnosis
- Diagnostic Imaging
- Dictionaries & Terminology
- Diet Therapy
- Diseases
- Education & Training
- Emergency Medicine
- Epidemiology
- Ethics
- Evidence-Based Medicine
- Gastroenterology
- Health Care Delivery
- Health Policy
- Hematology
- Histology
- History
- Infectious Diseases
- Instruments & Supplies
- Laboratory Medicine
- Mental Health
- Microbiology
- Nephrology
- Neurology
- Neuroscience
- Nosology
- Nursing Home Care
- Oncology
- Optometry
- Orthopedics
- Otorhinolaryngology
- Pain Medicine
- Pathophysiology
- Pediatrics
- Perinatology & Neonatology
- Pharmacology
- Physical Medicine & Rehabilitation
- Physician & Patient
- Podiatry
- Practice Management & Reimbursement
- Preventive Medicine
- Psychiatry
- Pulmonary & Thoracic Medicine
- Radiology & Nuclear Medicine
- Research
- Rheumatology
- Sports Medicine
- Terminal Care
- Test Preparation & Review
- Toxicology
- Tropical Medicine
- Ultrasonography
- Urology
- Acupuncture
- Biochemistry
- Embryology
- Family & General Practice
- Geriatrics
- Holistic Medicine
- Medicaid & Medicare
- Parasitology
- Physicians
- Reference
- Transportation
- Atlases
- Health Risk Assessment
- Lasers in Medicine
- Occupational & Industrial Medicine
- Bariatrics
- Chiropractic
- Home Care
- Osteopathy
- Caregiving
- Drug Guides
- Medical History & Records
- Pediatric Emergencies
- Prosthesis
- Administration
- Psychology
- Developmental
- Psychotherapy
- Psychopathology
- General
- Education & Training
- Interpersonal Relations
- Personality
- Clinical Psychology
- Cognitive Psychology
- Creative Ability
- Emotions
- Ethnopsychology
- Forensic Psychology
- History
- Human Sexuality
- Industrial & Organizational Psychology
- Mental Health
- Movements
- Neuropsychology
- Research & Methodology
- Social Psychology
- Suicide
- Applied Psychology
- Experimental Psychology
- Physiological Psychology
- Statistics
- Hypnotism
- Reference
- Practice Management
- Science & Math
Search